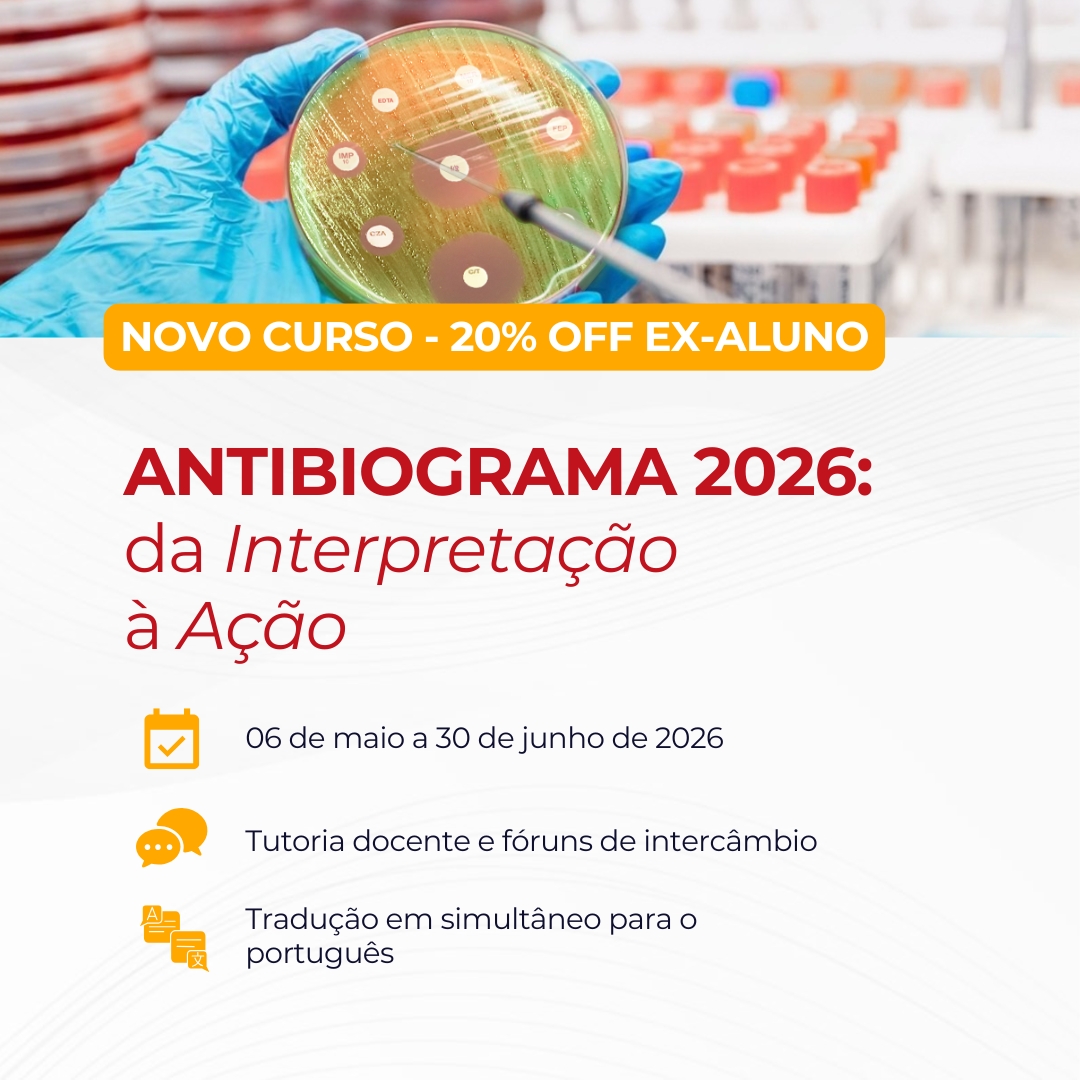

Introdução
O curso Multirresistência 2025: Abordagem integral das infecções na era dos microrganismos difíceis de tratar é organizado pela Rede de Educação Médica Contínua na Ibero-América (redEMC), em conjunto com a Associação Mexicana de Infectologia e Microbiologia Clínica (AMIMC) e a Sociedade Brasileira de Infectologia (SBI), com o apoio da Associação Panamericana de Infectologia (API).
Patrocínio Científico: da Sociedade Espanhola de Doenças Infecciosas e Microbiologia Clínica (SEIMC) e da Sociedade Portuguesa de Doenças Infecciosas e Microbiologia Clínica (SPDIMC).
Direcionado a: infectologistas, clínicos gerais, intensivistas, microbiologistas, bioquímicos, técnicos de laboratório, farmacêuticos, enfermeiros em controle de infecções e outros profissionais de saúde interessados.
Direção acadêmica a cargo do Dr. Juan Pablo Horcajada (SEIMC-Espanha), Dr. Javier Farina (SADI/SATI-Argentina), Dra. Patricia Rodríguez Zulueta (AMIMC-México) e Dr. Alberto Chebabo (SBI-Brasil).
Objetivo do curso:
- Fortalecer as competências clínicas e microbiológicas dos profissionais de saúde para o diagnóstico oportuno e a abordagem inicial de infecções causadas por microrganismos multirresistentes (MMR), incorporando ferramentas como escores clínicos, estudos de vigilância, novas metodologias diagnósticas e o uso otimizado de antimicrobianos.
- Fornecer critérios atualizados para a seleção e otimização do tratamento antimicrobiano, desde a terapia empírica até o tratamento direcionado, integrando fatores como o foco infeccioso, a epidemiologia local, os perfis de resistência e os princípios farmacocinéticos/farmacodinâmicos (Pk/Pd).
- Atualizar conhecimentos sobre o manejo específico de infecções por patógenos multirresistentes-chave, como Staphylococcus aureus MR, enterococos resistentes à vancomicina, enterobactérias produtoras de carbapenemases, bacilos gram-negativos não fermentadores multirresistentes e Clostridioides difficile, bem como infecções fúngicas por Candida spp.
- Promover a implementação efetiva de Programas de Otimização de Antimicrobianos (PROA) e de Diagnóstico Microbiológico (PRODIM) nos diferentes níveis de atenção, derrubando mitos sobre o tratamento antibiótico e fomentando a tomada de decisões baseada em evidências.
Duração: 1º de outubro a 25 de novembro de 2025
Carga horária: 30 horas de estudo.
Dedicação esperada: mínimo de 4 horas semanais, em horário livre administrado pelo participante. Baixar Programa
Sucesso!
Modalidade
O curso será desenvolvido online de 1º de outubro a 25 de novembro de 2024, através da plataforma redEMC. Oferece acesso em espanhol a materiais e atividades práticas especificamente desenhadas para esta proposta de educação continuada.
O progresso acadêmico será semanal, com a abertura de um novo módulo a cada quarta-feira a partir de 9 de outubro. Uma vez habilitado, os materiais de cada módulo permanecerão acessíveis on-demand.
A flexibilidade da atividade online permite que os participantes acessem o campus virtual de qualquer lugar e a qualquer momento.
Na seção "Módulos", que se encontra ao final desta página, será possível acessar cada um dos módulos acadêmicos.
Equipe Docente
(Diretor Acadêmico) Dr. Juan Pablo Horcajada. Chefe de Serviços de Doenças Infecciosas, Hospital Mar. Coordenador do Grupo de Pesquisa em Patologia Infecciosa e Antimicrobianos (IPAR). Barcelona - Espanha.
(Diretor Acadêmico) Dr. Javier Farina. Médico especialista em infectologia e clínica médica. Membro da SADI. Ex-diretor do comitê de infectologia crítica da SATI. Chefe de Infectologia do Hospital de Alta Complexidade Cuenca Alta e Hospital Mariano e Luciano de la Vega, Buenos Aires - Argentina.
(Diretora Acadêmica) Dra. Patricia Rodríguez Zulueta. Chefe da Divisão de Infectologia Adultos, Hospital “Dr. Manuel GEA González”, Cidade do México. Professora de Infectologia de graduação e pós-graduação na Universidade Nacional Autônoma do México (UNAM) e na Universidade La Salle. México
(Diretor Acadêmico) Dr. Alberto Chebabo. Diretor médico do Hospital Universitário «Clementino Fraga Filho», UFRJ. Presidente da Sociedade Brasileira de Infectologia. Brasil
(Coordenador Acadêmico) Dr. Alexandre Rodrigues da Silva. Infectologista. Doutor em Ciências.. Coordenador do Serviço de Controle de Infecção Hospitalar do Hospital Estadual Dório Silva e Hospital Meridional Serra. Atual 1o. Secretário da Sociedade Brasileira de Infectologia (SBI). Brasil
Dr. Rafael Cantón, PhD. Chefe do Departamento de Microbiologia. Hospital Universitário Ramón y Cajal. Professor Associado na Universidade Complutense, Madrid. Ex-presidente da SEIMC. Ex-presidente da EUCAST e Membro do Conselho Consultivo da Joint Programming Initiative Antimicrobial Resistance (JPIAMR). ESCMID Fellow. Espanha.
Dr. Ricardo Ferrer. Chefe do Serviço de Medicina Intensiva, Hospital Vall d'Hebron Barcelona, Espanha.
Dra. Silvia Gómez-Zorrilla, PhD. Médica assistente do Serviço de Doenças Infecciosas do Hospital del Mar. Hospital del Mar Research Institute. Professora associada da Universidade Pompeu Fabra. CIBERINFEC. Barcelona, Espanha.
Dra. Lorena López Cerero. Professora Titular de Microbiologia, Universidade de Sevilha, Andaluzia. Especialista em Microbiologia (UGC Microbiologia, Doenças Infecciosas e Medicina Preventiva), Hospital Universitário Virgen Macarena, Sevilha - Espanha.
Dra. Patricia Ruiz Garbajosa (Espanha) Serviço de Microbiologia, Hospital Universitário Ramón y Cajal & Instituto Ramón y Cajal de Investigação em Saúde (IRYCIS). Doenças Infecciosas (CIBERINFEC), Instituto de Saúde Carlos III, Madrid, Espanha.
Dra. Mila Montero. Chefe da Seção de Infecção Nosocomial, Serviço de Doenças Infecciosas, Hospital del Mar. Infectologista. Professora associada da Universitat Pompeu Fabra, Barcelona, Espanha.
Dr. Adrian Camacho Ortiz, PhD. Especialista em Infectologia e Clínica Médica, pela Universidade Autônoma de Nuevo León e Universidade Nacional Autônoma do México. Doutorado em Medicina na Universidade Autônoma de Nuevo León. Chefe de Departamento no Hospital Universitário “Dr. José Eleuterio González”, Monterrey, Nuevo León. México
Dra. Lorena Sandra Díaz Ortiz, PhD. Bacteriologista, PhD em Ciências Biológicas. Professora Associada, Pesquisadora do grupo de Genômica e Resistência Microbiana (GeRM) da Faculdade de Medicina, Universidade do Desenvolvimento - Clínica Alemã. Chile
Dr. Germán Esparza. Bacteriologista e microbiologista clínico. Professor de antimicrobianos nos programas de graduação e pós-graduação em microbiologia médica, Pontifícia Universidade Javeriana, Bogotá. Professor da residência em doenças infecciosas da Universidade del Rosario. Membro do painel de especialistas em microbiologia do CLSI dos Estados Unidos. Coordenador do comitê de microbiologia clínica da Associação Panamericana de Infectologia. Colômbia.
Dra. María Virginia Villegas. Infectologista, Mestre em Microbiologia e Fellow em Resistência Bacteriana. Diretora do laboratório de Resistência Antimicrobiana e Epidemiologia Hospitalar (RAEH) e Professora Adjunta da Universidade El Bosque. Colômbia
Dr. Arnaldo Lopes Colombo. Professor Titular de Disciplina de Doenças Infecciosas, Escola Paulista de Medicina - Universidade Federal, Brasil.
Dr. Claudio Querido Fortes. Professor Associado da Faculdade de Medicina da Universidade Federal do Rio de Janeiro e Professor Titular da Faculdade de Medicina da Universidade Estácio de Sá. Brasil
Dr. Diego Falci. Professor de Medicina na Pontifícia Universidade Católica do Rio Grande do Sul, Brasil, e médico infectologista do Hospital de Clínicas de Porto Alegre, Brasil.
Dra. Wanda Cornistein. Coordenadora do PROA e Chefe do Serviço de Prevenção e Controle de Infecções do Hospital Universitário Austral, acreditado pela Joint Commission International. Embaixadora em Controle de Infecções da Society for Healthcare Epidemiology of America SHEA 2021. Especialista em Docência Universitária (UBA) e Diretora do Mestrado em Prevenção e Controle de Infecções da Universidade Austral. Membro da Comissão Diretiva e Comissão de Infecções Associadas aos Cuidados de Saúde (IACS) da Sociedade de Infectologia da Argentina, SADI. Membro do Comitê de Infectologia Crítica da Sociedade Argentina de Terapia Intensiva (SATI).
Dra. Gabriela Zambrano. Professora de Doenças Infecciosas e Imunologia Clínica da Universidade Central do Equador. Professora de Clínica Médica da Universidade Internacional do Equador. Professora de pós-graduação da Pontifícia Universidade Católica do Equador. e Membro do Comitê Covid-19 da Associação Panamericana de Infectologia.
Dra. Nancy Sandoval. Professora titular de Clínica Médica da Universidade Rafael Landívar. Mestre Internacional em Doenças Parasitárias Tropicais pela Universidade de Valência, Espanha. Mestrado em Doenças Infecciosas do Hospital del Mar, Universidade Autônoma de Barcelona, Espanha. Ex-presidente da Associação Guatemalteca de Doenças Infecciosas (AGEI) e da Associação Centro-Americana e do Caribe de Infectologia (ACENCAI).
Apoiadores Acadêmicos
Premiamos a participação nos Fóruns de intercâmbio
Sabemos que compartilhar conhecimentos e experiências entre colegas enriquece o aprendizado de todos, começando por aqueles que decidem compartilhar o que sabem, por isso queremos destacar quem mais se envolver respondendo às perguntas dos colegas.
Suas contribuições não passarão despercebidas! Ao final do curso, premiaremos os 10 participantes que tenham demonstrado maior participação e compromisso nos fóruns, respondendo às dúvidas dos demais participantes. Esses participantes receberão como reconhecimento:
- Certificado especial como Colaborador Acadêmico.
- Reconhecimento do aumento das horas de dedicação, totalizando 40h.
- Uma bolsa integral para o curso de sua escolha em modalidade flexível.
À medida que participarem, os comentários com mais “curtidas” serão reconhecidos como recomendados, e os nomes dos participantes mais ativos aparecerão em um ranking especial.
Estamos ansiosos para aprender juntos!
Equipe Docente
Requisitos de aprovação
Atividade obrigatória M1: Rede Profissional
Atividade obrigatória M2: Simulação Clínica
Atividade obrigatória M3: Simulação Clínica
Atividade obrigatória M4: Simulação Clínica
Atividade obrigatória M5: Simulação Clínica
Atividade obrigatória M6: Simulação Clínica
Atividade obrigatória M7: Simulação Clínica
Atividade obrigatória M8: Compromisso de Mudança.
Quem cumprir esses requisitos dentro do prazo estipulado, obterá um certificado de aprovação indicando a carga horária, emitido pela organização do curso.
Quem cumprir apenas alguns requisitos, mas não todos, obterá uma constância de participação emitida pela organização do curso.
Uma vez que complete os requisitos de aprovação estabelecidos e identificados como tal no campus, poderá solicitar durante as "Atividades finais" sua certificação na seção 'Módulos' que será exibida na parte direita de cada módulo, sempre que esteja habilitado de acordo com seu progresso educacional.
Por favor, revise — e modifique se necessário — o nome que aparece em seu perfil de usuário, pois será utilizado para a confecção dos certificados. Uma vez solicitada sua certificação, será enviado um e-mail com o link para download.
ATENÇÃO: Só terá duas tentativas para corrigir o nome e sobrenome em seu certificado. Depois de solicitado, poderá baixá-lo quantas vezes for necessário a partir de seu e-mail ou de seu perfil neste campus virtual.
Regras básicas de comportamento na rede
1. Nunca se esqueça de que a pessoa que lê a mensagem é humana, com sentimentos que podem ser feridos.
2. Adote online os mesmos padrões de comportamento que você segue na vida real.
3. Escrever tudo em maiúsculas é considerado como gritar e, além disso, dificulta a leitura.
4. Respeite o tempo e a largura de banda das outras pessoas.
5. Mostre o melhor do seu lado enquanto estiver online.
6. Compartilhe seu conhecimento com a comunidade.
7. Ajude a manter os debates em um ambiente saudável e educativo.
8. Respeite terceiros; criar um grupo contra uma pessoa é errado.
9. Não abuse do seu poder.
10. Perdoe os erros dos outros.

Comentários gerais do curso "MULTIRRESISTÊNCIA 2025: Abordagem integral das infecções na era dos microrganismos de difícil tratamento"